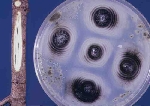
Verticillium Solgunluğu Hastalığı Belirtileri, Nedenleri Ve Mücadelesi

Verticillium Solgunluğu Hastalığı Belirtileri, Nedenleri Ve Mücadelesi
Verticillium Solgunluğu Hastalığı
(Verticillium Dahliae)
VERTİSİLYUM SOLGUNLUĞU HASTALIK BELİRTİSİ
Hastalığın ani ve yavaş solgunluk olmak üzere 2 tip belirtisi bulunmaktadır.

Ani solgunluk: Bu durum kış sonundan erken ilkbahara kadar görülür. Sürgün ve dallar aniden kurur. Bu belirtiler ağacın tek bir yönünde veya daha çok yönünde olabilir. Kabuk dokusu erguvan rengine döner. Böyle bir dalın kabuğunun altından boyuna kesitler alındığında iletim demetleri koyu kestane renge dönüştüğü görülür. Hastalıklı ağaçların sürgün ve dalları kuruyarak ölür. Yapraklar yeşilimsi renklerini kaybederek açık kahverengine döner ve orta damar boyunca geriye doğru kıvrılır.

Yavaş solgunluk: İlkbaharda görülmeye başlar. Çiçeklerdeki belirtiler yapraklardan önce ortaya çıkar. Hastalık çiçeklenme döneminin başında olursa çiçekler dökülebilir. Mumyalaşan çiçek tomurcukları kahverengileşerek ölür ve ağaçta asılı kalır. Hastalıklı dallardaki yapraklar önce mat yeşil renklidir. Uç yapraklar dışındakiler kurumadan dökülür. Hastalıklı sürgünlerde iletim demetleri koyu kahverengidir. Hastalık zeytin ağaçlarında verim düşüklüğü ve ölüme neden olmaktadır.

VERTİSİLYUM SOLGUNLUĞU HASTALIĞIN GÖRÜLDÜĞÜ BİTKİLER
Zeytin, sert çekirdekli meyve türleri, badem, antepfıstığı, asma, berberis, akçaağaç, atkestanesi, karaağaç, böğürtlen, karpuz, çilek, pamuk, bamya, şerbetçiotu, domates, biber, patlıcan, ayçiçeği, begonya, gül, yabancı otlar başta olmak üzere çok geniş bir konukçu dizisi vardır.
VERTİSİLYUM SOLGUNLUĞU MÜCADELE YÖNTEMLERİ
Kültürel Önlemler
Sağlıklı üretim materyali kullanılmalı, Daha önce hastalığın görülmediği alanlarda zeytinlik tesis edilmelidir. Ancak hastalığın konukçusu olan bitkilerin tarımının yapıldığı yerlerde yetiştiricilik yapılacaksa bu topraklarda en az 2 yıl V.dahliae'nin konukçusu olmayan arpa, yulaf, buğday gibi tahıllar yetiştirildikten sonra zeytinlik tesis edilmelidir.
Toprak işleme yüzeysel ve ağacın taç izdüşümüne girmeden yapılmalıdır. Gübreleme yaprak ve toprak analiz sonuçlarına göre yapılmalıdır. Aşırı azotlu gübrelemeden kaçınılmalıdır. Aşırı sulama ve salma sulama yapılmamalıdır. Zeytin bahçelerinde hastalığın bulaşma ve taşınma riskini arttırdığı için kesinlikle ara tarım yapılmamalı, yabancı otlarla da mücadele edilmelidir.
Hastalıklı sürgünler budanmalı, yapraklar dökülmeden önce budama tamamlanmalı ve budama artıkları bahçeden uzaklaştırılmalıdır. Budama aletleri %10'luk çamaşır suyu ile dezenfekte edilmelidir. Kültürel tedbirlerin yanı sıra hastalık etmenin topraktaki yoğunluğunu azaltmak için solarizasyon uygulanabilir.
- Ahmet ünver
- ***@sorhocam.com
- adem şahin atabey
- ***@